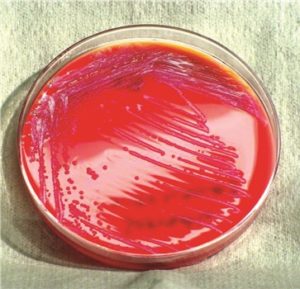

Профессор Университета в Висконсине-Стаут вместе со своими студентами сделали важное открытие, которое может помочь в определении причин гибели пчел во время зимовки. Профессор биологии Джим Буррит и его студенты опубликовали исследования новейшего штамма бактерии Serratia marcescens, которое подтвердило его губительную силу. Ученые присвоили этой бактерии название sicaria, что значит «убийца», для целей научных было использовано сокращение Ss1.
Важно рассказать читателям о некоторых особенностях этого патогена. Serratia marcescens, известная также как кровавая палочка или чудесная палочка, принадлежит к семейству Enterobacteriaceae и обладает его биологическими особенностями – клеточным строением без оболочки.
Бактерия эта является не спорообразующей, грамоотрицательной и относительно бескислородной и способна передвигаться с помощью жгутиков. Температурный режим, необходимый для ее жизнедеятельности, составляет 10-36ºC при pH 5-9. Для лабораторных исследований этой бактерии важен факт, что она вырабатывает энзим каталазу и ферментирует глюкозу.
Характерной особенностью, отличающей эти палочки от других Enterobacteriaceae является их способность производить три гидролитических энзима – деоксирибонуклеазу, желатиназу и липазу. Бактерия охотно создает колонии на крахмале, содержащимся в хлебобулочных изделиях и синтезирует красный пигмент, называемый продигиозином. Этот пигмент может быть причиной некоторых так называемых религиозных евхаристических чудес, во время которых на католических облатках, символизирующих тело Христово, появляются пятна крови.
Бактерия эта является патогенной, особенно для людей с врожденными нарушениями иммунитетом. Она иногда обнаруживается в составе микрофлоры пищеварительной системы человека и может быть причиной долго не заживающих ран и трудно поддающихся лечению инфекций мочевыделительных путей.
Serratia marcescens может вызывать острый коньюктивит либо быть причиной заражений во время пребывания в больнице. Группу особого риска представляют пациенты с новообразованиями, у которых может развиться воспаление легких, бактериальный сепсис или бактериальный менингит. Вызывает понос у детей. Большинство штаммов бактерии резистентны к целой гамме макролидных антибиотиков и бета-лактамов.
Профессор Бурритт, который также имеет свою пасеку, утверждает, что результаты его исследований указывают на то, что бактерии Ss1 могут быть причиной гибели пчелиных колоний в зимний период. Большое число пчеловодов на этой территории каждую зиму утрачивает более половины ульев. Так, например, в графстве Данн Каунти (Dunn County) падеж пчел в зимний период достиг за последние годы около 80%.
Эти бактерии можно увидеть под световым микроскопом в мазке гемолимфы, полученной от больных пчел из Данн Каунти. Научные работники, занимающиеся генетикой бактерий и биохимией в Университете Висконсин-Мэдисон, использовали метод масс-спектрометрии и три независимых геномных метода для подтверждения факта, что этот патоген ранее не был описан в научной литературе.
С большой долей вероятности можно утверждать, что открыта новая болезнь в пчеловодстве. Университет Висконсин-Стаут проводил исследования среди пасек в 8-ми западно-центральных округах штата Висконсин и восточных округах Минессоты. Было получено 91 пробников из ульев для проведения тестов.
Бурритти и его студенты протестировали 3219 медоносных пчел и, при случае, 1259 клещей Varroa destructor, полученных в период от декабря 2014 до сентября 2018. Штамм Ss1 был найден в пчелах и клещах в каждом пробнике из каждого округа-графства.
В 48% всех пробников были обнаружены новые бактерии, а 76% всех пробников содержали клещей. Из всех пчелосемей, погибших зимой, 73% показали наличие новых вышеуказанных бактерий. Одним из переломных открытий во время исследований стал тот факт, что клещи также переносят бактерию Ss1 – до этого считалось, что переносчиками этих паразитов являются только грозные для пчел вирусы.
Студенты провели два скриннинг-теста на базе биохимических особенностей с целью идентификации Ss1. Их научная программа также включала в себя микроскопный анализ гемолимфы медоносных пчел на наличие факторов заражения и обозначение белков в крови, отвечающих за иммунную систему.
Исследования доказали, что бактерии Ss1 имеют 65 генов, не идентифицированных у других видов Serratia, что дает повод утверждать, что Ss1 имеют генетическую информацию, «взятую в долг» от бактерий другого вида, т.е дошло до генетической рекомбинации.
В мазке гемолимфы зараженных бактерией Ss1 пчел было видно уменьшенное число клеток, отвечающих за защиту от бактериальных инфекций, что указывает на способность Ss1 ослаблять иммунную систему пчел.
По неутешительным данным организации The Bee Informed Partnership (http://beeinformed.org), в 2015-2018 годах гибель пчелиных семей в США и Европе была на уровне 44%, что на 3,5% выше, чем в предыдущем году и на 12,5% выше, чем в 2013-2014 годах.
Наиболее известные бактериальные инфекции, которые выступают в улье – это болезни личинок, в первую очередь американский и европейский гнилец. Возбудителем американского гнильца являются эндоспоры бактерии Paenibacillus larvae, тогда как гнилец европейский вызывают бактерии Melissococcus plutonius.
Симптомы обоих видов подобны. Serratia marcescens предположительно вызывает инфекцию, но нет ни одного научного доказательства ее связи с патогенами, вызывающими гнилец. Примерами других бактериальных инфекций являются Bacillus pulvifaciens и вид Spiroplasma, который отвечает за майскую болезнь пчел.
Из пробников мертвых пчел, полученных выборочно из 24 среди 33 погибших ульев, были выделены бактерии, из которых большинство находилось на клещах Varroa, что подтверждает механизм распространения этой бактерии этими клещами.
Инфекция пчел, вызванная Ss1 связана с редукцией защитных гемоцитов в организме пчел, в результате чего начинается сепсис, приводящий в конечном итоге к гибели насекомых. Исследования доказывают, что инфекция может значительно сократить жизнь пчел.
Для классификации пробников из групп живых пчел были использованы три критерия.
Первым критерием классификации было отделение имеющих симптомы пчел от пчел без симптомов болезни. Общим симптомом зараженных трутней и рабочих пчел была утраченная способность к нормальному движению.
Рабочие пчелы с симптомами, живые, но неподвижные, были собраны с верхней части зимнего клубка в конце декабря-начале января. В сезоне, во время теплых месяцев были найдены также неподвижные трутни.Вторым критерием были зараженные и свободные от бактерий пчелы, которых были подвергнуты скриннинг-тестам.Третьим критерием было общее разделение на рабочие пчелы и трутни. На наличие культур Ss1 в гемолимфе были проверены 4 группы и в последствии было выделено:
— Зараженные рабочие пчелы с симптомами (symptomatic infected workers), сокращенно SIW;
— Зараженные рабочие пчелы без симптомов (asymptomatic infected workers), сокращенно AIW;
— Не зараженные рабочие пчелы без симптомов (asymptomatic uninfected workers), сокращенно AUW;
— Зараженные трутни с симптомами (symptomatic infected drones), сокращенно SID.
Группа ученых взяла также анализы из полостей мертвых пчел, содержащих гемолимфу, а также из кала пчел, собранных ранней весной, что стало важным материалом для проведения микробиологических скриннинг-тестов.
Гемолимфа пчел была размещена в среде LB, содержащей агар, в последствие несколько стекол Петри находились в инкубаторе в температуре 22°C в течение 3-х дней. За это время удалось вырастить мощные популяции бактерий Ss1. Культуры были взяты у мертвых пчел из 33 погибших семей, у 24 из которых было подтверждено наличие штамма Ss1.
Из всей группы исследуемых ульев 33 случайно выбранных семьи были проверены на клещи, из них 25 (76%) имело клещи с положительным результатом на бактерию Ss1. В группе, состоящей из 91 улья, в 66 случайно выбранных семьях (как живых, так и мертвых) были взяты пробники и в 32 семьях (48%) было подтверждено наличие культуры Ss1.
В этой группе зиму не пережили 33 пчелиные семьи – это открытие было сделано в период c 1 января по 1 апреля. Пробники из этих семей послужили материалом для исследований. В 24 ульях их 33 (73%) подтверждено наличие культуры Ss1. Профессор Бурритт ясно дает оценку ситуации. Хотя исследования еще не дают окончательного ответа, как можно предотвратить гибель пчел зимой, однако дают новый взгляд на болезни пчел и, следовательно, новые пути борьбы с ними.